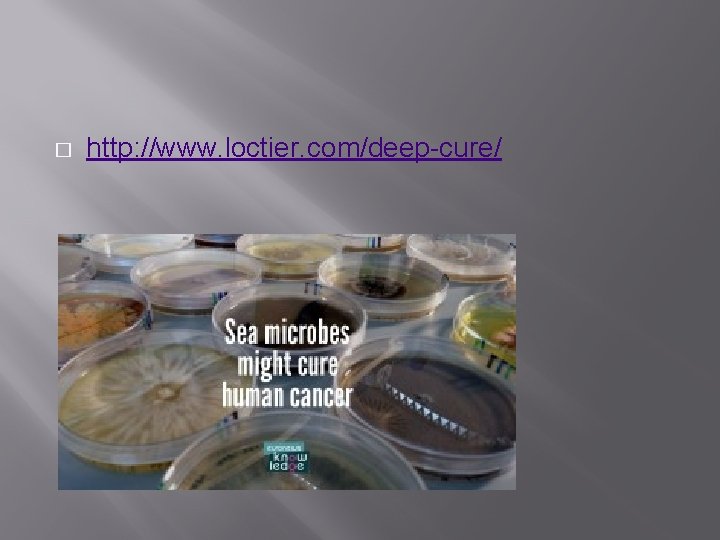
� http: //www. loctier. com/deep-cure/

CH 5 THE MICROBIAL WORLD Microbes critical role

CH. 5: THE MICROBIAL WORLD

Microbes �critical role in evolution � most important primary producers directly/indirectly feed most marine life � make nutrient available & recycles organic matter

5. 1 Prokaryotes � � � � simplest & oldest carry out all chemical processes that more complex organism & many unique to prok. cell wall, cell membrane no membrane-bound organelles circular DNA Bacteria & Archaea Structurally simple compared to other cells found in other kingdoms

A. Bacteria (domain Bacteria) � � � genetically different than archaea & euk. abundant in all parts of ocean & range of metabolic activities shapes-spheres, spirals, rods, & rings depending on species � causing water change color (red tides) � cause skin rashes on humans � live on seaweed and algae called epiphytes � endophytes live in algae

Stromatolites � https: //www. youtube. com/watch? v=D 73 Tgy. HQFE&list=PL 031898 EA 9887 CCB 3&in dex=182 � Planktonic cyanobacteria Build mounds, living bacteria the top Go through Photosythnesis � �

Decay bacteria � � Break down waste products and dead organic matter Recycle essential nutrients Abundant in bottom sediment heterotrophs

Cyanobacteria � Thought to be most abundant photosynthetic organism in the ocean � Red tides are caused by cyanobacteria that contain a red pigment called dinoflagellates

B. Archaea (domain Archaea) � 3. 8 billion years old � spiral, rod, sphere, or spiral-shaped � more closely related to euk. than bacteria � found in extreme environments-extremophiles � very deep water experiencing 300 to 800 atms � hydrothermal vents 158º-176ºF � most extreme 250ºF � Salty environments like salt pans & deep ocean basins � High acid or alkaline conditions

Archaea Video Clip � https: //www. youtube. com/watch? v=l. Tv. Pb 4 shg. V I

Archeabacteria Cont. � � � hypothesis that archaea only live in extreme environments is false new techniques w/nucleic acid sequences prove they are common found in water column & sediments

C. Prokaryote Metabolism � � 1. The Biological Species Concept What is a species? A type of organism? -Chemical reactions -obtain energy in more than one way

2. Autotrophs (bacteria and archaea) � � � make own food-primary producers photoautotrophic (cyanobacteria) use photosynthetic pigments on folded membranes to capture sunlight to make organic matter and O 2 some use the light emitted from hydrothermal vents to perform chemosynthesis where there is no sunlight

Autotrophs Cont. some photosynthetic bacteria are unique have chlorophyll that helps produce S instead of O 2 & store light energy in ATP � archaeum lacks chlorophyll but has pigments that converts light energy to ATP � chemosynthetic/chemoautotrophic bacteria make H 2 S and other S, N, & Fe compound instead of glucose � chemosynthetic/chemoautotrophic archaeum produce methane �

Autotrophs/Heterotrophs Video Clip � https: //www. youtube. com/watch? v=y. Ws. Uf. ITQl Ns � https: //www. youtube. com/watch? v=l. Tv. Pb 4 shg. V I

3. Heterotrophs � � most marine bacteria obtain energy from organic matter by aerobic/anaerobic respiration many are decomposers anaerobic use sulfate (SO 42 -) instead of O 2 producing H 2 S giving rotten egg smell to some sediments

4. nitrogen fixation � � � bottom dwelling & cyanobacteria fix the food chain by converting gaseous nitrogen (N 2) into ammonium (NH 4+) which is used by primary producers requires ATP Chemosynthesis-Make food by obtaining chemical compounds (not directly from light)

5. 2 Unicellular Algae � � � diverse, eukaryotic, & mostly photosynthetic photosynthesis occurs in chloroplasts color due to pigment concentrations simple reproductive structures lack specialized tissues of plants range in size from single cell to large multicellular seaweeds

A. Diatoms � � � Unicellular, aggregate into chains and star-like organisms Eukaryotic planktonic

Diatoms Cont. � � cell walls of silica, Si. O 2 two tightly fitted frustules looking like elongated boxes allows light to pass through minute perforations allow dissolved gases & nutrients enter & exit open ocean diatoms slow to sink because of oil droplets in cells & spines

� � efficient photosynthetic factories in temperate & polar regions most planktonic but some produce stock-like structures for attachment colorless live as heterotrophs on seaweed produce toxins that accumulates in shellfish & plankton eating fishes serious or fatal illness in humans

Diatoms Cont. � � � asexual reproduction-cell division sexual reproduction-egg & sperm favorable conditions=rapid reproduction producing blooms � diatom get smaller & smaller because of asexual reproduction � depletion of silicate � dead diatoms cover ocean floor producing diatomaceous earth (biogenous sediment) � diatomaceous toothpaste earth used for filters, insulators, and

Diatomaceous Earth � � is a naturally occurring chalk-like sedimentary rook that is easily crumbled into a white to offwhite powder. The powder has an abrasive feel. Diatomaceous Earth typically contains 86% silica, 5% sodium, 3% magnesium and 2% iron. Used in toothpastes, make-ups, etc.

B. Dinoflagellates � � � planktonic primary producers & unicellular two flagella used for directed movement cell wall made of cellulose plates may have spines, pores or other ornaments most photosynthesize, some also ingest food particles asexually-cell division

� � � blooms (red tides) produce toxins than can pass to shellfish seafood may be poisonous during red tides https: //www. youtube. com/watch? v=OUe. AMzo. K NWg

� � Bioluminescence https: //www. youtube. com/watch? v=o. Kj. FVBVGa d 0

� � Dinoflagellates are symbiotic with, sponges, anemones, and coral reefs are called zooxanthellae parasitic of seaweeds and marine animals

Harmful Dinoflagellates � � � Pfiesteria spends most of life as harmless cyst Open sores on fishes Sores & temporary memory loss in humans

C. Other Unicellular Algae � silicoflagellates � star-shape � internal skeleton coccolithophorids � spherical cells with button like ornamented (coccoliths) � cryptophytes � lack skeleton � chloroplasts contained w/in reduced eukaryotic cells (symbiotic)

5. 3 Protozoans: Animal-Like Protists � � � eukaryotic, unicellular, heterotrophic, some contain chlorophyll some form colonies find them in sediment with organic debris, surface of seaweeds, guts of animals Some are heterotrophs; some are autotrophs Their name derives from first animals Included in Protista

A. Foraminiferans (Forams) � � Shells made from calcium carbonate microscopic & several chambers for increase growth form foraminiferan ooze-high concentration over large area of sea floor limestone & chalk beds around world are foram sediments uplifted from ocean floor

� � � pseudopodia long retractable extensions of cytoplasm protrude through pores in shells trap diatoms & other organisms then move into interior cell

Foraminaferan Cont. � � � � bottom dwellers, either free or attached single cell can be 5 cm few planktonic shell smaller & thinner spines that aid in floatation form microfossils Shell is temperature sensitive & geologist estimate past temperatures of the ocean

B. . Radiolarians � � � planktonic, producing delicate silica shells microscopic, but can form colonies 9 ft in length open ocean, shells settle on bottom forming radiolarian ooze in deep water

C. Ciliates � � � cilia (hair-like structures) used for locomotion & feeding in sediment, seaweed, gills of clams, intestine of sea urchins, skin of fish form colonies

� � tintinnids drift in water & build loricas (vase-like cases) made of sand grains or transparent Facilitate energy flow of dissolved organic matter to larger plankton

5. 4 Fungi � � � � mostly multicellular eukaryotes heterotrophs-lack chloroplasts & cannot perform photosynthesis mostly microscopic decompose detritus parasites of marine sea grasses or borer in mollusk shells cause disease in economical seaweed, sponges, shellfish, & fish used in antibiotics
� http: //www. loctier. com/deep-cure/

Fungi Cont. � � Symbiotic relationship w/algae to form lichens (part of lichens) filament growths of fungus helps algae support algae provides food for fungus lichens form dark brown black patches in wave zones in North Atlantic
- Slides: 38